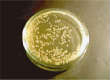
ムッシュ使用前
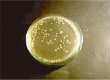
ムッシュ使用後180分経過
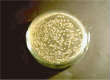
ムッシュ使用前
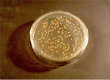
ムッシュ使用後180分経過
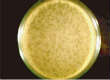
ムッシュ使用前

抗菌データ
耐性菌や病原菌に対する抗菌効果の検証
| 試験菌名 | 接種直後 | 試験試料 | 減菌率(%) | |
|---|---|---|---|---|
| 200ルクス18時間後 | 暗所24時間後 | |||
| 0-157大腸菌 | 1.8×105 | ムッシュ | 98.39 | 99.76 |
| 1.8×105 | 外部用 | 0 | 0 | 1.8×105 | 光触媒なし | 0 | 0 |
| MRSA (院内感染を引き 起す菌種) |
2.5×105 | ムッシュ | 99.99 | 99.99 |
| 2.5×105 | 外部用 | 92.80 | 0 | 2.5×105 | 光触媒なし | 0 | 0 |
【試験機関】財団法人日本食品分析センター
200ルクス1時間後に対する抗菌効果の検証
| 試験菌名 | 試験試料 | 試験開始時 | 減菌率(%) | |
|---|---|---|---|---|
| 200ルクス18時間後 | 暗所24時間後 | |||
| 大腸菌 | ムッシュ | 3.5×104 | <10 | 99.99 |
| 外部用 | 3.5×104 | 1.3×104 | 62.86 | 光触媒なし | 3.5×104 | 3.4×104 | - |
| 黄色 ブドウ球菌 |
ムッシュ | 8.5×104 | <100 | 99.88 |
| 外部用 | 8.5×104 | 9.0×103 | 89.41 | 光触媒なし | 8.5×104 | 3.4×104 | - |
【試験機関】佐賀大学農学部微生物研究室
大腸菌
蛍光灯[紫外線強度:20uw/cm2]
0min

180min
暗所[紫外線強度:0uw/cm2]
180min
0min
黄色ブドウ球菌
蛍光灯[紫外線強度:20uw/cm2]

0min

180min
暗所[紫外線強度:0uw/cm2]
180min

0min
Tファージ
蛍光灯[紫外線強度:20uw/cm2]
0min

180min
暗所[紫外線強度:0uw/cm2]

180min

0min









